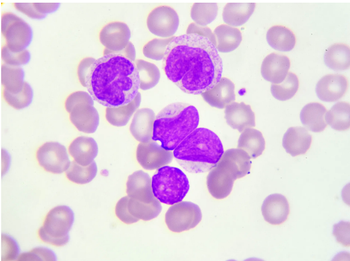

Chronic Lymphocytic Leukemia
Latest News
Latest Videos

CME Content
More News

A leukemia clinical pharmacy specialist delves into the significance of educating patients on treatments and serving as a resource for both patients and health care providers.

The pharmacist can assist with managing drug interactions, patient education, therapy selection, physician education, and more.

The investigators advise that the use of bendamustine should be avoided when possible in patients with refractory LBCL who are potential candidates for CAR T-cell therapy.

Although treatment is effective, AEs remain difficult for patients.

This is the first trial to show that a measurable residual disease (MRD)–guided approach with treatment beyond MRD negativity has a significant advantage over chemotherapy, both in terms of progression-free survival and overall survival.

Pirtobrutinib is the first and only non-covalent BTK inhibitor to be approved by the FDA and is indicated for adult patients who already received at least 2 prior lines of therapy.

Although vaccination status and the severity of COVID-19 infection were not correlated, the timing of vaccine administration influenced whether patients had severe COVID-19 infection.

The acceptance comes after results from TRANSCEND CLL 004, which is the first trial to demonstrate clinical benefit with a CAR T cell therapy in patients who were previously treated for CLL or SLL.

The use of base editing to generate universal, off-the-shelf CAR T cells is a promising approach for relapsed leukemia, with potential implications for the future of gene therapy.

A low dose of the combination treatment inhibited AML cell cycle and increased apoptosis.

Lisaftoclax Granted FDA Clearance for Phase 3 Trial in Patients With Chronic Lymphocytic Leukemia, Small Lymphocytic Lymphoma
Lisaftoclax is a novel, oral, small-molecule, BCL-2 selective inhibitor being evaluated for treatment of relapsed/refractory chronic lymphocytic leukemia or small lymphocytic lymphoma.

With a better understanding of the underlying pathophysiology of chronic lymphocytic leukemia and the introduction of novel targeted agents, such as Bruton kinase Inhibitors, the prognosis of high-risk patients has changed dramatically.

Irreversible Bruton tyrosine kinase inhibitor produces positive results in patients with relapsed/refractory marginal zone lymphoma.

Pirtobrutinib is a non–covalent (reversible) BTK inhibitor, demonstrating a 73.3% overall response rate with a median follow-up of 19.4 months among patients with chronic lymphocytic leukemia or small lymphocytic lymphoma.

In-person visits to receive oral therapy, outpatient infusions, and inpatient infusion for the treatment of hematologic neoplasms declined in the early months of the COVID-19 pandemic, while telemedicine use increased slightly in the same period but remained low overall.

Long-term data show that venetoclax combinations benefit progression free survival and overall survival in patients with or without previous treatment for chronic lymphocytic leukemia.
Expert said that manufacturing the T cells with a tyrosine kinase inhibitor may allow more patients to get allogeneic stem cell transplant, the current best means of long-term cure.

Obe-cel Shows Promise in Treatment of Relapsed/Refractory B-cell Acute Lymphoblastic Leukemia
Obe-cel is an investigational CD19 CAR T-cell therapy currently in clinical trials for relapsed/refractory B-cell acute lymphoblastic leukemia and B-cell non-Hodgkin lymphoma.

Study shows 18.4% of patients with relapsed or refractory chronic lymphocytic leukemia treated with lisocabtagene maraleucel achieved a complete response (CR), with median duration of CR not reached at median follow-up of 21.1 months.

Program Chair Ryan Haumschild, PharmD, MS, MBA, discussed what attendees can look forward to at the inaugural Oncology Pharmacists Connect meeting.

Since 2014, 10 immunotherapies have been approved by the FDA, including 6 CAR T-cell therapies and 4 BiTE therapies.

CRISPR technology has also been successful in treating a pediatric patient with T-cell acute lymphoblastic leukemia, showing feasibility of its use for cancer immunotherapy.

At 36 months, the overall survival rate of patients with relapsed/refractory B-cell acute lymphoblastic leukemia administered brexucabtagene autoleucel was 47.1%, with a median overall survival of 26 months.

In her closing thoughts, Dr Mahmoudjafari provides an overview of cardiovascular implications associated with CLL as well as the impact of pharmacists in CLL treatment management.

Dr Mahmoudjafari explores the role of BTK inhibitors in the treatment of CLL.










































































































































